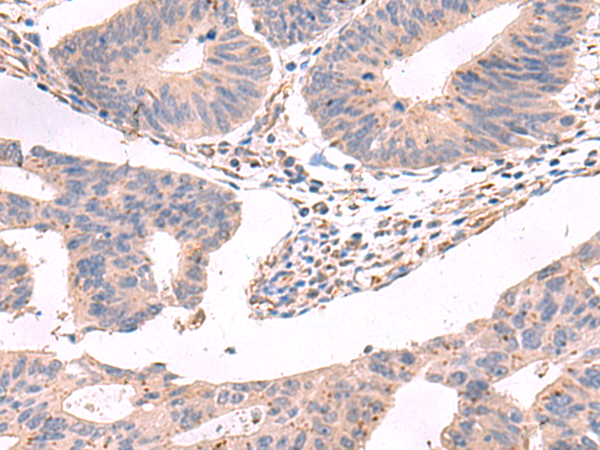

中文名稱: 兔抗GKAP1多克隆抗體
標 記 物: Unconjugate
|
Background: |
This gene encodes a protein that is highly similar to the mouse cGMP-dependent protein kinase anchoring protein 42kDa. The mouse protein has been found to localize with the Golgi and recruit cGMP-dependent protein kinase I alpha to the Golgi in mouse testes. It is thought to play a role in germ cell development. Transcript variants encoding different isoforms have been found for this gene. |
|
Applications: |
ELISA, IHC |
|
Name of antibody: |
GKAP1 |
|
Immunogen: |
Fusion protein of human GKAP1 |
|
Full name: |
G kinase anchoring protein 1 |
|
Synonyms: |
FKSG21; GKAP42 |
|
SwissProt: |
Q5VSY0 |
|
ELISA Recommended dilution: |
5000-10000 |
|
IHC positive control: |
Human cervical cancer and Human colorectal cancer |
|
IHC Recommend dilution: |
90-450 |

購物車
購物車 幫助
幫助
 021-54845833/15800441009
021-54845833/15800441009
